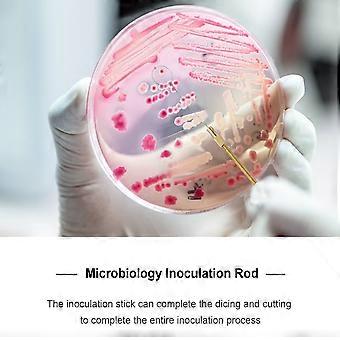
product image

Eease 1 Pc Laboratory Inoculation Stick Experiment Inoculation Rod Inoculation Ring
envío GRATUITO

Eease 1 Pc Laboratory Inoculation Stick Experiment Inoculation Rod Inoculation Ring
- Marca: Unbranded
Eease 1 Pc Laboratory Inoculation Stick Experiment Inoculation Rod Inoculation Ring
- Marca: Unbranded
Ahorre 9,00 € (37%)
PVP
Política de devoluciones de 14 días
Ahorre 9,00 € (37%)
PVP
Política de devoluciones de 14 días
Métodos de pago:
Descripción
Eease 1 Pc Laboratory Inoculation Stick Experiment Inoculation Rod Inoculation Ring
- Marca: Unbranded
- Categoría: Tubos de ensayo
- Nº de Fruugo : 442358289-928703263
- EAN: 9329698263605
Información de seguridad del producto
Consulte la información de seguridad del producto específica de este producto que se describe a continuación.
La siguiente información es proporcionada por el minorista independiente que vende este producto.
Entrega y devolución
Enviado en un plazo de 3 días
-
STANDARD: GRATIS - Entrega entre mar 20 enero 2026–mié 28 enero 2026 - GRATIS
Envío desde China.
Hacemos todo lo posible para asegurarnos de que se le entreguen los productos que pida en su totalidad y de acuerdo con sus especificaciones. Sin embargo, si recibe un pedido incompleto o artículos diferentes a los que pidió, o hay alguna otra razón por la que no está satisfecho con el pedido, puede devolver el mismo o cualquier producto incluido en él y obtener un reembolso completo por los artículos. Vea la política de devolución completa
Detalles de cumplimiento del producto
Consulte la información de cumplimiento específica de este producto que se describe a continuación.
La siguiente información es proporcionada por el minorista independiente que vende este producto.
Fabricante:
La información que se proporciona a continuación incluye los datos de contacto del fabricante del producto de referencia a la venta en Fruugo.
- Yang Yue
- Lixian Penghui Trading Co., Ltd.
- Group 5
- Renhe Tun
- Lixian Changde
- Changde City
- CN
- 415500
- yangzhilingyzl@outlook.com
- +1(319)277-0024
Persona responsable en la UE:
La información que se proporciona a continuación incluye la información de contacto de la persona responsable en la UE. La persona responsable es el agente económico designado con sede en la UE responsable de las obligaciones de cumplimiento en relación al producto de referencia a la venta en la UE.
- eVatmaster Consulting GmbH
- eVatmaster Consulting GmbH
- Raiffeisen Street2 B1l
- Rodgau
- DE
- 63110
- contact@evatmaster.com
- +49 61062699873